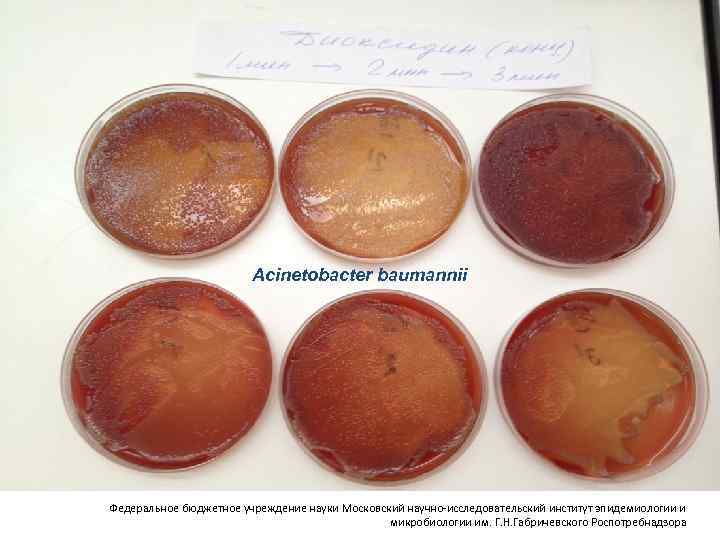
Acinetobacter baumannii Федеральное бюджетное учреждение науки Московский научно-исследовательский институт эпидемиологии и микробиологии им. Г.

3 Инфекционная безопасность пациентов ОРИТ.ppt
- Количество слайдов: 66

Инфекционная безопасность пациентов ОРИТ Ольга Ершова

«Если я оглянусь на кладбища, где схоронены зараженные в госпиталях, то не знаю, чему больше удивляться: стоицизму ли хирургов, или доверию, которым продолжают пользоваться госпитали у правительства и общества. Можно ли ожидать истинного прогресса, пока врачи не вступят на новый путь и не примутся общими силами уничтожать источники госпитальных миазм? » Пирогов Н. И. Начала общей военно-полевой хирургии. – М. – Л. , 1944 год

Notes on Matters Affecting the Health, Efficiency and Hospital Administration of the British Army, 1858 Заметки о факторах, влияющих на здоровье, эффективность и управление госпиталями британской армии Notes on Nursing: What It Is and What It Is Not, 1860 Как нужно ухаживать за больными Флоренс Найтингейл 12 мая 1820 - 13 августа 1910 «Уход должен быть разумным, и, в сущности, он сводится к внешне малозаметным, но чрезвычайно важным мелочам»

Пневмония - ИОХВ - SSI PNEU Большая 4 BIG FOUR Инфекции кровотока - BSI Инфекции МВП - UTI CDC|NHSN Surveillance Definition of Healthcare-Associated Infection and Criteria for Specific Types of Infections in the Acute Care Setting, 2009

медработники антисептики для рук пациенты ВОЗБУДИТЕЛИ ВБИ антибиотики внешняя среда дезинфицирующие средства антисептики

Гигиена рук IA IB Защитная одежда IB Дезинфекция оборудования IB Изоляция пациентов с VRE, MRSA KRAB, KRKP и индивидуальный уход IB Дезинфекция поверхностей в окружении пациента IB Контроль инфекций и обучение IB Управление антибиотикотерапией Микробиологический мониторинг Профилактика девайс-ассоциированных инфекций

Профилактика инфекций кровотока


15% пациентов после постановки центрального венозного катетера страдают от инфекционных, тромботических и других осложнений, требующих его удаления Mc. Gee D, Gould M. Preventing complications of central venous catheterization. N Engl J Med 2003; 348: 1123– 33

Трудности классификации 1. 2. 3. 4. 5. 6. Колонизированный катетер Инфекция места введения катетера Карманная инфекция Туннельная инфекция Инфекция, связанная с инфузией Катетер-ассоциированная инфекция кровотока Бережанский Б. В. , Жевнерев А. А. Катетер-ассоциированные инфекции кровотока //Клин. микробиол. антимикроб. химиотер. – 2006. – Т. 8. – №. 2. – С. 130 -144.

Horan T. C. , Andrus M. , Dudeck M. A. CDC/NHSN surveillance definition of health care–associated infection and criteria for specific types of infections in the acute care setting //American journal of infection control. – 2008. – Т. 36. – №. 5. – С. 309 -332.

A. Первичная ИКР Флебит Лабораторно подтвержденная без клинических признаков Лабораторно подтвержденная с клиническими признаками Клинический сепсис B. Вторичная ИКР Подтвержденная вторичная бактериемия Вероятная вторичная бактериемия Лабораторно подтвержденная с клиническими признаками Клинический сепсис Асланов Б. И. , Зуева Л. П. , Любимова А. В. , Колосовская Е. Н. и др. Эпидемиологическое наблюдение за инфекциями, связанными с оказанием медицинской помощи. Федеральные клинические рекомендации. – М. , 2014. – 58 с.

Катетерассоциированные инфекции кровотока первичная бактериемия (или фунгемия) у пациента с сосудистым катетером и системными проявлениями инфекции при выделении одного и того же патогена из крови и катетера

Allegranzi B. et al. Burden of endemic health-care-associated infection in developing countries: systematic review and meta-analysis //The Lancet. – 2011. – Т. 377. – №. 9761. – С. 228 -241.

Rosenthal V. D. et al. International Nosocomial Infection Control Consortium report, data summary of 50 countries for 2010 -2015: Device-associated module //American journal of infection control. – 2016. – Т. 44. – №. 12. – С. 1495 -1504.


Летальность (28 дн ) была существенно выше у возрастных пациентов, пациентов с хроническими болезнями органов дыхания либо с иммунодефицитом. Септический шок с ПОН, высокий индекс оценки SOFA в начале HA-BSI были независимыми факторами риска

Tabah A. et al. Characteristics and determinants of outcome of hospital-acquired bloodstream infections in intensive care units: the EUROBACT International Cohort Study //Intensive care medicine. – 2012. – Т. 38. – №. 12. – С. 1930 -1945.


Основные правила инфекционной безопасности

Пути контаминации катетера Выполните обработку рук спиртовым антисептиком

Эндогенные Кожные покровы Преимущественно Гр+ бактерии Протекция – уход за кожей, повязка Экзогенные Источник инфекции – другие пациенты Преимущественно Гр- бактерии Путь передачи – руки медицинских работников при постановке и уходе

Что определяет эффективность профилактики КАИК? Профилактика экзогенного инфицирования Профилактика эндогенного инфицирования Гигиена рук и портов Гигиена кожи Дезинфекция поверхностей Защита раны повязкой Материал катетера

Профилактика КАИК Strategies to Prevent CLABSI До постановки катетера: 1. Постановка катетера строго по показаниям 2. Образование 3. Ежедневная гигиена кожи Постановка катетера: 1. Чек-лист 2. Гигиена рук 3. Избегать использования бедренной вены у взрослых тучных пациентов 4. Использовать готовый набор на катетеризацию 5. Обеспечивать максимальный уровень стерильности при постановке ЦВК 6. Использовать спиртовой раствор хлоргексидина для деконтаминации кожи в месте постановки ЦВК После постановки: 1. Оптимальное соотношение медсестра-пациент 2. Дезинфекция портов перед каждым входом 3. Своевременное удаление катетера 4. Прозрачные повязки на 5 -7 дней 5. Контроль КАИК SHEA/IDSA Practice Recommendation: Executive Summary A Compendium of Strategies to Prevent Healthcare-Associated Infections in Acute Care Hospitals: 2014 Updates

Правила постановки ЦВК • Соблюдение максимальных барьерных мер предосторожности • Полное накрывание пациента стерильной хирургической простыней

препарат для гигиены рук преимущества имеют спиртосодержащие препараты средство для рук с оптимальной антимикробной эффективностью содержит 75% -85% этанола, изопропанола или н-пропанола или сочетают эти продукты ВОЗ, Руководство по гигиене рук

Препараты для гигиены рук и гигиены кожи перед постановкой ЦВК – это разные препараты:

волосы в области введения катетера следует удалить непосредственно перед введением катетера, используя специальные клиперы. бритье волос бритвои запрещено ! для обработки кожи используют спиртосодержащие препараты фиксация катетера – подшивание к коже или безшовная фиксация устройством

• С целью обеспечения ежедневного контроля состояния раны, • надежнои фиксации ЦВК, • минимизации механических повреждении кожи при смене повязки и • защиты раны входного отверстия катетера от контаминации извне используют прозрачную повязку





Замена повязки на ЦВК



Индивидуальный столик со средствами для ухода за пациентом

Стратегия профилактики 1. Перекрестная передача патогенов - стандартные меры предосторожности - дезинфекция поверхностей в близком окружении пациента 2. Эндогенное инфицирование -гигиена кожи -стерильная постановка -стерильная смена повязки -длительное использование повязки с возможностью визуализации места входа ЦВК 3. Образование и обратная связь

Число ИК (абс. ч. ) 2012 21 2013 15 2014 25 2015 19 2016 11

Этиология инфекций кровотока (%) Staphylococcus aureus Staphylococcus Со. N Serratia marcescens Klebsiella pneumoniae Acinetobacter baumannii Proteus mirabilis Pseudomonas aeruginosa Candida sp 2011 год 16 13 3 32 10 10 0 12 2012 год 5 5 0 48 24 9 0 0 2013 год 2014 год 20 11 40 43 13 0 13 14 7 7 7 0 0 10 0 3 2015 год 5 47 5 10 5 0 10 6 2016 год 21 7 7 14 0 0 0 14

Профилактика инфекций места хирургического вмешательства

The 23 types of surgery that were included in the study were all less than 1. Conclusion: As well as antibiotic prophylaxis being a generally effective intervention for preventing postoperative wound infection, the level of this effectiveness would appear to be reasonably independent of what type of surgery is being considered. Антибиотикопрофилактика в целом эффективна для предотвращения послеоперационной раневой инфекции, и уровень эффективности представляется достаточно независимым от того, какой тип операции рассматривается. Bowater R. J. , Stirling S. A. , Lilford R. J. Is antibiotic prophylaxis in surgery a generally effective intervention? : testing a generic hypothesis over a set of meta-analyses //Annals of surgery. – 2009. – Т. 249. – №. 4. – С. 551 -556.

Общие подходы к проведению ПАП: • Одна доза антибиотика внутривенно до начала операции • Двойная доза у пациентов с массой тела более 90 кг • Вторая доза при продолжительности операции более 6 часов • Курс терапии АМП у пациентов с подтвержденной инфекцией

Меры, направленные на предотвращение перекрестной передачи патогенов Источник инфекции пациент: Антибиотики и антисептики Уход за кожей и слизистыми Путь передачи контактный: Дезинфекция поверхностей Гигиена рук Стандартные меры предосторожности


Чувствительность пациента к инфекции Неблагоприятный прогноз жизни в случае инфицирования Наличие инвазивных устройств – ЦВК, дренажи, МК, ИВЛ Агрессивность лечебных и диагностических процедур

Эффективность антисептиков Klebsiella pneumoniaе Хлоргексидин 0, 05% Бигуаидин 1, 5± 0, 5*10 2 ООО "Лекарь", Диоксидин (разбавлен)-40% Диоксидин, ОАО Мосхимфармпрепар ат им. Н. А. Семашко, Acinetobacter baumannii Мирамистин ЧАС 6, 0± 0, 5*10 2 ООО"Инфамед" Гидроксиметилхи ноксалиндиоксид сплошной рост Хлоргексидин 0, 05% сплошной рост сплошно й рост Гидроксиметилхиноксалин диоксид сплошной рост ООО "Лекарь", Диоксидин (разбавлен)-40% Диоксидин, ОАО Мосхимфармпрепарат им. Н. А. Семашко, Все умрут, а я останусь! Бигуаидин

Хлоргексидин • Klebsiella pneumoniae – 8 штаммов • Pseudomonas aerugonosae – 3 штамма • Acinetobacter baumani – 4 штамма • Pr. mirabilis – 3 штамма • Хлоргексидин 0, 05% - препарат в аптечной сети Хлоргексидин р-р наружн 0. 05% Е. В. Детушева, В. Б. Родин, П. В. Слукин, О. Н. Ершова, И. А. Александрова, Н. В. Курдюмова, С. Ю. Сазыкина, И. А. Дятлов, Н. К. Фурсова Чувствительность нозокомиальных штаммов K. pneumoniae, P. aeruginosa, A. baumannii и P. mirabilis к антисептику на основе хлоргексидина Клин Микробиол Антимикроб Химиотер. 2015; 17(1): 57 -66

Концентрацию ХБ следует увеличить в 20 – 25 раз!!! МБК методом аппликаторов (модель «биоплёнок» ) для клебсиелл и ацинетобактеров оказалась в диапазоне от 1563 до 6250 мг/л (или 0, 16 -0, 63%) Соответственно инактивацию этих микроорганизмов следует проводить 1 % раствором дезина (по действующему веществу). МБК методом аппликаторов (модель «биоплёнок» ) для протея оказалась очень высокой – 12500 мг/л и выше (1, 25% и выше). Е. В. Детушева, В. Б. Родин, П. В. Слукин, О. Н. Ершова, И. А. Александрова, Н. В. Курдюмова, С. Ю. Сазыкина, И. А. Дятлов, Н. К. Фурсова Чувствительность нозокомиальных штаммов K. pneumoniae, P. aeruginosa, A. baumannii и P. mirabilis к антисептику на основе хлоргексидина Клин Микробиол Антимикроб Химиотер. 2015; 17(1): 57 -66

Acinetobacter baumannii Федеральное бюджетное учреждение науки Московский научно-исследовательский институт эпидемиологии и микробиологии им. Г. Н. Габричевского Роспотребнадзора

Какой препарат выбрать для дезинфекции? • Действующее вещество и его концентрация • Гибель наиболее резистентного патогена – Cl. difficile и разрушение биопленок • Возможность использования в присутствие пациентов

Какой препарат выбрать для дезинфекции? • Механизм действия – окисление • Кислородактивные соединения – пербораты, перкарбонаты, диоксид хлора • Хлорактивные соединенеия – на основе органических соединений – натриевая соль дихлоризоциануровой кислоты

Режим применения ДС • концентрация • время действия • температура раствора

Концентрация ! Выживает сильнейший

БИОПЛЕНКИ




Загрязнение палат после пациентов напрямую связано с внутрибольничными инфекциями, вызванными Clostridium difficile. Использование двух передвижных импульсных ксеноновых ультрафиолетовых установок было введено в практику дезинфекции помещений в больнице общего профиля. Число инфекций, вызванных Clostridium difficile, составляло 9, 46 на 10 000 пациенто-дней; Далее это количество снизилось до 4, 45 на 10 000 пациенто-дней (снижение на 53%, P =0, 01). Количество смертей и колэктомий связанных с С. difficile также значительно снизилось.

Предотвращено 29 случаев внутрибольничных инфекций C. difficile При стоимости лечения одного случая внутрибольничной инфекции в 13 500 долларов, потенциальная экономия составила примерно 300 000 долларов

Альтернативные технологии контроля ИСМП – Бактериофаги?

Бактериофаги при ИСМП Энтеральное применения бактериофагов Системный механизм действия Штаммоспецифический антифаговый иммунный ответ Быстрое изменение циркулирующих штаммоввозбудителей ИСМП

Бактериофаги при ИСМП Закрепление видового состава коктейля бактериофагов с последующим подбором ( «адаптацией» ) фаговых штаммов из имеющейся фено- и генотипически охарактеризованной коллекции Использование различных штаммовых составов для пациентов в различных стационарах Прогнозируемая клиническая эффективность использования бактериофагов у конкретных пациентов

Что мы можем сделать для контроля инфекций в ОРИТ ? Мониторинг инфекций, обратная связь, обучение Гигиена рук = 90% Контроль за использованием АМП Набор мер по предупреждению ИК, И ДС, ИОХВ Дезинфекция поверхностей с учетом резистентности патогенов Разобщение пациентов, выделяющих резистентные патогены Протоколы выполнения «стерильных» процедур

Благодарю за внимание
3 Инфекционная безопасность пациентов ОРИТ.ppt